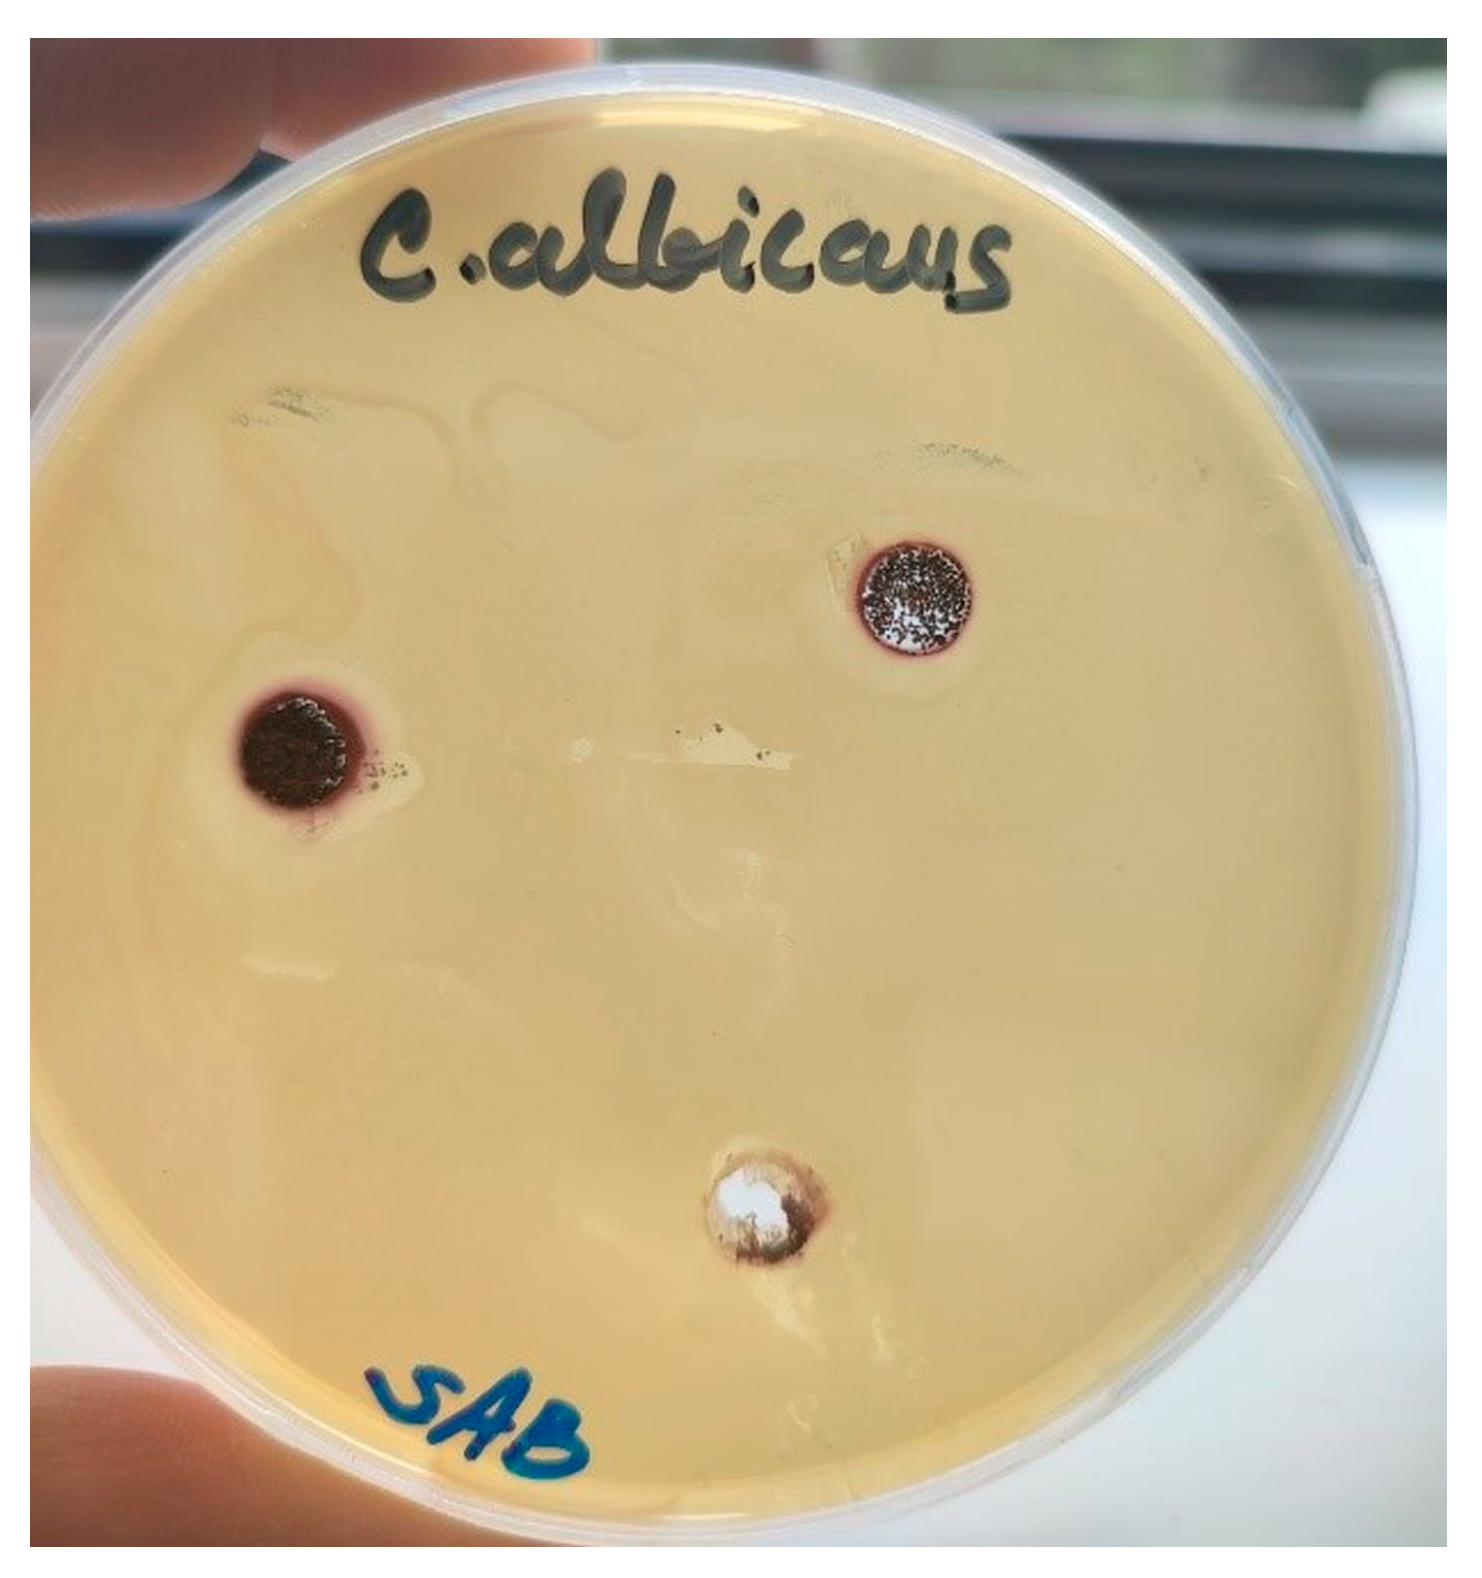

Fast Gold Recovery from Aqueous Solutions and Assessment of Antimicrobial Activities of Novel Gold Composite
Abstract
:1. Introduction
2. Materials and Methods
2.1. Reagents
2.2. Preparation of Polymeric Adsorbent
2.3. Adsorption Experiments
2.4. Methods of Characterization
2.5. Antibacterial Activity Assay
3. Results and Discussion
3.1. Adsorbent Characterization
3.2. Adsorption Kinetics
3.3. The Mechanism of Gold Adsorption onto pGME-en
3.4. Characterization of Gold Polymer Composite
3.5. Antimicrobial Evaluation of Gold Polymer Composite
4. Conclusions
Supplementary Materials
Author Contributions
Funding
Data Availability Statement
Acknowledgments
Conflicts of Interest
References
- Syed, S. Recovery of Gold from Secondary Sources—A Review. Hydrometallurgy 2012, 115–116, 30–51. [Google Scholar]
- Yuan, W.; Chen, X.; Xu, Y.; Yan, C.; Liu, Y.; Lian, W.; Zhou, Y.; Li, Z. Preparation and Recyclable Catalysis Performance of Functional Macroporous polyHIPE Immobilized with Gold Nanoparticles on Its Surface. RSC Adv. 2018, 8, 5912–5919. [Google Scholar] [PubMed]
- Gökelma, M.; Birich, A.; Stopic, S.; Friedrich, B. A Review on Alternative Gold Recovery Re-Agents to Cyanide. J. Mater. Sci. Chem. Eng. 2016, 04, 8–17. [Google Scholar]
- Wang, C.; Lin, G.; Zhao, J.; Wang, S.; Zhang, L.; Xi, Y.; Li, X.; Ying, Y. Highly Selective Recovery of Au(III) from Wastewater by Thioctic Acid Modified Zr-MOF: Experiment and DFT Calculation. Chem. Eng. J. 2020, 380, 122511. [Google Scholar]
- Guo, J.; Luo, X.; Tan, S.; Ogunseitan, O.A.; Xu, Z. Thermal Degradation and Pollutant Emission from Waste Printed Circuit Boards Mounted with Electronic Components. J. Hazard. Mater. 2020, 382, 121038. [Google Scholar]
- Forti, V.; Baldé, C.P.; Kuehr, R.; Bel, G. The Global E-Waste Monitor 2020: Quantities, Flows and the Circular Economy Potential; United Nations University/United Nations Institute for Training and Research: Bonn, Germany; International Telecommunication Union: Geneva, Switzerland; International Solid Waste Association: Rotterdam, The Netherlands, 2020. [Google Scholar]
- Zhao, W.; Yang, B.; Yi, Y.; Feng, Q.; Liu, D. Synergistic Activation of Smithsonite with Copper-Ammonium Species for Enhancing Surface Reactivity and Xanthate Adsorption. Int. J. Min. Sci. Technol. 2023, 33, 519–527. [Google Scholar] [CrossRef]
- Shen, Z.; Wen, S.; Wang, H.; Miao, Y.; Wang, X.; Meng, S.; Feng, Q. Effect of Dissolved Components of Malachite and Calcite on Surface Properties and Flotation Behavior. Int. J. Miner. Metall. Mater. 2023, 30, 1297–1309. [Google Scholar]
- Dangi, Y.R.; Bediako, J.K.; Lin, X.; Choi, J.-W.; Lim, C.-R.; Song, M.-H.; Han, M.; Yun, Y.-S. Polyethyleneimine Impregnated Alginate Capsule as a High Capacity Sorbent for the Recovery of Monovalent and Trivalent Gold. Sci. Rep. 2021, 11, 17836. [Google Scholar]
- Dzhardimalieva, G.I.; Uflyand, I.E. Synthetic Methodologies for Chelating Polymer Ligands: Recent Advances and Future Development. ChemistrySelect 2018, 3, 13234–13270. [Google Scholar]
- Huang, P.; Zhang, Y.; Wang, B.; Zhu, X.; He, Y.; Song, P.; Wang, Z.; Wang, R. Synthesis of Acryloyl Copolymer Core–Shell Microspheres with Antibacterial Activity and Surface Cationic Effects. J. Mater. Sci. 2023, 58, 7718–7730. [Google Scholar]
- Liu, J.; Wang, N.; Liu, J.; Li, M.; Xu, Y.; Wang, C.; Wang, Y.; Zheng, H.; Ma, L. The Immobilization of Pd(II) on Porous Organic Polymers for Semihydrogenation of Terminal Alkynes. ACS Appl. Mater. Interfaces 2020, 12, 51428–51436. [Google Scholar] [CrossRef] [PubMed]
- Marković, B.M.; Vuković, Z.M.; Spasojević, V.V.; Kusigerski, V.B.; Pavlović, V.B.; Onjia, A.E.; Nastasović, A.B. Selective Magnetic GMA Based Potential Sorbents for Molybdenum and Rhenium Sorption. J. Alloys Compd. 2017, 705, 38–50. [Google Scholar]
- Mehdinia, A.; Salamat, M.; Jabbari, A. Preparation of a Magnetic Polystyrene Nanocomposite for Dispersive Solid-Phase Extraction of Copper Ions in Environmental Samples. Sci. Rep. 2020, 10, 3279. [Google Scholar] [CrossRef]
- Poupart, R.; Grande, D.; Carbonnier, B.; Le Droumaguet, B. Porous Polymers and Metallic Nanoparticles: A Hybrid Wedding as a Robust Method toward Efficient Supported Catalytic Systems. Prog. Polym. Sci. 2019, 96, 21–42. [Google Scholar] [CrossRef]
- Pourjavadi, A.; Kohestanian, M.; Keshavarzi, N. Immobilization of Au Nanoparticles on Poly(Glycidyl Methacrylate)-functionalized Magnetic Nanoparticles for Enhanced Catalytic Application in the Reduction of Nitroarenes and Suzuki Reaction. Appl. Organomet. Chem. 2020, 34, e5828. [Google Scholar] [CrossRef]
- Trofin, M.; Racovita, S.; Vasiliu, S.; Bargan, A.; Bucatariu, F.; Vasiliu, A.; Mihai, M. Synthesis of Crosslinked Microparticles Based on Glycidyl Methacrylate and N-Vinylimidazole. Macromol. Chem. Phys. 2023, 2300253. [Google Scholar] [CrossRef]
- Suručić, L.T.; Nastasović, A.B.; Onjia, A.E.; Janjić, G.V.; Rakić, A.A. Design of Amino-Functionalized Chelated Macroporous Copolymer [Poly(GMA-EDGMA)] for the Sorption of Cu (II) Ions. J. Serb. Chem. Soc. 2019, 84, 1391–1404. [Google Scholar] [CrossRef]
- Vasiliu, S.; Lungan, M.; Racovita, S.; Popa, M. Porous Microparticles Based on Methacrylic Copolymers and Gellan as Drug Delivery Systems. Polym. Int. 2020, 69, 1066–1080. [Google Scholar] [CrossRef]
- Melo, C.; Silva, L.; Costa, L.; Marques, M. Synergistic Effect of Adsorption and Enzymatic Conversion in the Bisphenol-A Removal by Laccase Immobilized on Poly(Glycidyl Methacrylate-Co-Ethyleneglycol Dimethacrylate). J. Braz. Chem. Soc. 2017, 28, 2192–2201. [Google Scholar] [CrossRef]
- Zhang, J.; Man, H.; Han, X.; Wang, Z.; Jiang, Y. Facile Preparation of Magnetic P(MMA-Co-GMA)@Fe3O4@PMAA Microspheres Using Porous Microsphere as Templates for Removal of Methylene Blue. Colloid Polym. Sci. 2023, 301, 933–947. [Google Scholar] [CrossRef]
- Xie, W.; Xiong, Y.; Wang, H. Fe3O4-Poly(AGE-DVB-GMA) Composites Immobilized with Guanidine as a Magnetically Recyclable Catalyst for Enhanced Biodiesel Production. Renew. Energy 2021, 174, 758–768. [Google Scholar] [CrossRef]
- Jovanović, S.M.; Nastasović, A.; Jovanović, N.N.; Jeremić, K. Targeted Porous Structure of Macroporous Copolymers Based on Glycidyl Methacrylate. MSF 1996, 214, 155–162. [Google Scholar]
- Ekmeščić, B.M.; Maksin, D.D.; Marković, J.P.; Vuković, Z.M.; Hercigonja, R.V.; Nastasović, A.B.; Onjia, A.E. Recovery of Molybdenum Oxyanions Using Macroporous Copolymer Grafted with Diethylenetriamine. Arab. J. Chem. 2019, 12, 3628–3638. [Google Scholar] [CrossRef]
- Jovanović, S.; Nastasović, A. Macroporous Glycidyl Methacrylate Copolymers, Synthesis, Characterization and Application. In Polymeric Materials; Nastasović, A., Ed.; Transworld Research Network: Kerala, India, 2009; pp. 1–27. [Google Scholar]
- Marković, B.M.; Maksin, D.D.; Mojović, Z.D.; Vuković, Z.M.; Nastasović, A.B.; Jovanović, D.M. Electrochemical Behavior of Palladium Modified Amino-Functionalized Macroporous Copolymer. J. Electroanal. Chem. 2017, 786, 94–101. [Google Scholar] [CrossRef]
- Marković, B.M.; Stefanović, I.S.; Nastasović, A.B.; Sandić, Z.P.; Suručić, L.T.; Dapčević, A.; Džunuzović, J.V.; Jagličić, Z.; Vuković, Z.M.; Pavlović, V.B.; et al. Novel Magnetic Polymer/Bentonite Composite: Characterization and Application for Re(VII) and W(VI) Adsorption. Sci. Sinter. 2021, 53, 419–428. [Google Scholar] [CrossRef]
- Nastasović, A.; Jovanović, S.; Jakovljević, D.; Stanković, S.; Onjia, A. Noble Metal Binding on Macroporous Poly(GMA-Co-EGDMA) Modified with Ethylenediamine. J. Serb. Chem. Soc. 2004, 69, 455–460. [Google Scholar] [CrossRef]
- Suručić, L.; Tadić, T.; Janjić, G.; Marković, B.; Nastasović, A.; Onjia, A. Recovery of Vanadium (V) Oxyanions by a Magnetic Macroporous Copolymer Nanocomposite Sorbent. Metals 2021, 11, 1777. [Google Scholar] [CrossRef]
- Ebraheem, K.A.K.; Mubarak, M.S.; Yassien, Z.J.; Khalili, F. Chelation Properties of Poly(8–Hydroxyquinoline 5,7–Diylmethylene) Crosslinked with Bisphenol–A Toward Lanthanum(III), Cerium(III), Neodimium(III), Samarium(III), and Gadolinium(III) Ions. Sep. Sci. Technol. 2000, 35, 2115–2125. [Google Scholar] [CrossRef]
- Palza, H. Antimicrobial Polymers with Metal Nanoparticles. Int. J. Mol. Sci. 2015, 16, 2099–2116. [Google Scholar] [CrossRef]
- Erol, İ.; Özer, M. Copolymers of a Novel Amphiphilic Methacrylate Monomer Based on the Hydroxyl Group: Copolymerization Kinetics, Thermal Properties, Biological Activity, and Swelling Behavior. J. Polym. Res. 2021, 28, 372. [Google Scholar] [CrossRef]
- Hanaa, D.; Youssef, A.; El-Metwally, E.; Abdelaal, M. Preparation and Characterization of Novel Poly(MMA-Co-GMA)/Ag Nanocomposites for Biomedical Applications. Egypt. J. Chem. 2019, 62, 2245–2252. [Google Scholar] [CrossRef]
- Vukoje, I.D.; Džunuzović, E.S.; Vodnik, V.V.; Dimitrijević, S.; Ahrenkiel, S.P.; Nedeljković, J.M. Synthesis, Characterization, and Antimicrobial Activity of Poly(GMA-Co-EGDMA) Polymer Decorated with Silver Nanoparticles. J. Mater. Sci. 2014, 49, 6838–6844. [Google Scholar] [CrossRef]
- Malović, L.; Nastasović, A.; Sandić, Z.; Marković, J.; Đorđević, D.; Vuković, Z. Surface Modification of Macroporous Glycidyl Methacrylate Based Copolymers for Selective Sorption of Heavy Metals. J. Mater. Sci. 2007, 42, 3326–3337. [Google Scholar] [CrossRef]
- Marković, B.; Spasojević, V.; Dapčević, A.; Vuković, Z.; Pavlović, V.; Randjelović, D.; Nastasović, A. Characterization of Glycidyl Methacrylate Based Magnetic Nanocomposites. Hem. Ind. 2019, 73, 25–35. [Google Scholar] [CrossRef]
- Suručić, L.; Janjić, G.; Marković, B.; Tadić, T.; Vuković, Z.; Nastasović, A.; Onjia, A. Speciation of Hexavalent Chromium in Aqueous Solutions Using a Magnetic Silica-Coated Amino-Modified Glycidyl Methacrylate Polymer Nanocomposite. Materials 2023, 16, 2233. [Google Scholar] [CrossRef]
- Mujbil, H.H.; Al Jebur, L.A.; Yousif, E.; Kadhom, M.; Mohammed, A.; Ahmed, D.S.; Ali, M.; Hashim, H. Utilization of Metal Oxides Nanoparticles in Modulating Polyvinyl Chloride Films to Resist Ultraviolet Light. Metals 2022, 12, 1413. [Google Scholar] [CrossRef]
- Martins, T.R.; Costa, P.S.; Bertuol, D.A.; Aguiar, M.L.; Tanabe, E.H. Development of Recycled Expanded Polystyrene Nanofibers Modified by Chitosan for the Removal of Lead(II) from Water. Metals 2022, 12, 1334. [Google Scholar] [CrossRef]
- Qin, M.; Zong, S.; Zhang, P.; Li, J. Sustainable Route for Synthesis of Nitrogen-Doped Carbon Dots with High Efficiency for Iron(III) and Copper(II) Ions Detection. J. Mater. Sci. 2023, 58, 7559–7570. [Google Scholar] [CrossRef]
- Rezaei, A.; Hadian-Dehkordi, L.; Samadian, H.; Jaymand, M.; Targhan, H.; Ramazani, A.; Adibi, H.; Deng, X.; Zheng, L.; Zheng, H. Pseudohomogeneous Metallic Catalyst Based on Tungstate-Decorated Amphiphilic Carbon Quantum Dots for Selective Oxidative Scission of Alkenes to Aldehyde. Sci. Rep. 2021, 11, 4411. [Google Scholar] [CrossRef]
- Nastasović, A.; Marković, B.; Suručić, L.; Onjia, A. Methacrylate-Based Polymeric Sorbents for Recovery of Metals from Aqueous Solutions. Metals 2022, 12, 814. [Google Scholar] [CrossRef]
- Fouad, M. Validation of Adsorption-Desorption Kinetic Models for Fipronil and Thiamethoxam Agrichemicals on Three Soils in Egypt. Egypt. J. Chem. 2022, 66, 219–222. [Google Scholar] [CrossRef]
- Cheng, Y.; Chen, R.; Wang, P.; Wang, Q.; Wan, S.; Huang, S.; Su, R.; Song, Y.; Yang, X.; Fu, X. Synthesis of a Novel Biochar-Supported Polycarboxylic Acid-Functionalized Nanoiron Oxide-Encapsulated Composite for Wastewater Treatment: Removal of Cd(II), EDTA and Cd-EDTA. J. Mater. Sci. 2021, 56, 18031–18049. [Google Scholar] [CrossRef]
- Zubieta, C.E.; Messina, P.V.; Luengo, C.; Dennehy, M.; Pieroni, O.; Schulz, P.C. Reactive Dyes Remotion by Porous TiO2-Chitosan Materials. J. Hazard. Mater. 2008, 152, 765–777. [Google Scholar] [CrossRef] [PubMed]
- Lin, X.; Wang, L.; Jiang, S.; Cui, L.; Wu, G. Iron-Doped Chitosan Microsphere for As(III) Adsorption in Aqueous Solution: Kinetic, Isotherm and Thermodynamic Studies. Korean J. Chem. Eng. 2019, 36, 1102–1114. [Google Scholar] [CrossRef]
- Aghaei, E.; Alorro, R.; Encila, A.; Yoo, K. Magnetic Adsorbents for the Recovery of Precious Metals from Leach Solutions and Wastewater. Metals 2017, 7, 529. [Google Scholar] [CrossRef]
- Seyedhakimi, A.; Bastami, S.A.; Ghassa, S.; Razavi, H.; Chehreh Chelgani, S. Exploring Relationships between Various Activations of Granular Activated Carbon on Silver and Gold Adsorption: A Kinetic and Equilibrium Study. Sep. Sci. Technol. 2019, 54, 1710–1721. [Google Scholar] [CrossRef]
- Pan, H.-W.; Iizuka, A.; Shibata, E. Gold Recovery from Dilute Aqueous Solution by a Biosorbent Derived from Woody Biomass. Chem. Eng. Commun. 2021, 208, 1711–1724. [Google Scholar] [CrossRef]
- Geng, Y.; Li, J.; Lu, W.; Wang, N.; Xiang, Z.; Yang, Y. Au(III), Pd(II) and Pt(IV) Adsorption on Amino-Functionalized Magnetic Sorbents: Behaviors and Cycling Separation Routines. Chem. Eng. J. 2020, 381, 122627. [Google Scholar] [CrossRef]
- Mihăilescu, M.; Negrea, A.; Ciopec, M.; Davidescu, C.M.; Negrea, P.; Duţeanu, N.; Rusu, G. Gold (III) Adsorption from Dilute Waste Solutions onto Amberlite XAD7 Resin Modified with L-Glutamic Acid. Sci. Rep. 2019, 9, 8757. [Google Scholar] [CrossRef]
- Liu, F.; Peng, G.; Li, T.; Yu, G.; Deng, S. Au(III) Adsorption and Reduction to Gold Particles on Cost-Effective Tannin Acid Immobilized Dialdehyde Corn Starch. Chem. Eng. J. 2019, 370, 228–236. [Google Scholar] [CrossRef]
- Xiang, Y.; Liu, Y.; Li, M.; Bai, W.; Liu, G.; Xu, L. The Recovery of Au(III) by Hydrogel-like Beads. Hydrometallurgy 2023, 215, 105964. [Google Scholar] [CrossRef]
- Liu, F.; Zhou, L.; Wang, W.; Yu, G.; Deng, S. Adsorptive Recovery of Au(III) from Aqueous Solution Using Crosslinked Polyethyleneimine Resins. Chemosphere 2020, 241, 125122. [Google Scholar] [CrossRef] [PubMed]
- Xiong, C.; Wang, S.; Zhang, L. Selective Recovery Mechanism of Au(III) from an Aqueous Solution by Trimethyl Phosphate Modified Poly(Glycidyl Methacrylate). J. Taiwan Inst. Chem. Eng. 2019, 95, 55–64. [Google Scholar] [CrossRef]
- Xiong, C.; Wang, S.; Zhang, L.; Li, Y.; Zhou, Y.; Peng, J. Preparation of 2-Aminothiazole-Functionalized Poly(Glycidyl Methacrylate) Microspheres and Their Excellent Gold Ion Adsorption Properties. Polymers 2018, 10, 159. [Google Scholar] [CrossRef] [PubMed]
- Mohabey, H. IR Spectra, Magnetic and Thermal Studies of Copper (II) Complex of N-Hydroxy-N-(4-Chloro) Phenyl N’(4-Fluoro) Phenyl Benzamidine Hydrochloride. Mat. Sci. Res. India 2014, 11, 63–65. [Google Scholar] [CrossRef]
- Xu, L.; Liu, Y.; Wang, J.; Tang, Y.; Zhang, Z. Selective Adsorption of Pb2+ and Cu2+ on Amino-Modified Attapulgite: Kinetic, Thermal Dynamic and DFT Studies. J. Hazard. Mater. 2021, 404, 124140. [Google Scholar] [CrossRef]
- Xu, H.; Zhou, K.; Si, J.; Li, C.; Luo, G. A Ligand Coordination Approach for High Reaction Stability of an Au–Cu Bimetallic Carbon-Based Catalyst in the Acetylene Hydrochlorination Process. Catal. Sci. Technol. 2016, 6, 1357–1366. [Google Scholar] [CrossRef]
- Ravi, S.; Zhang, S.; Lee, Y.-R.; Kang, K.-K.; Kim, J.-M.; Ahn, J.-W.; Ahn, W.-S. EDTA-Functionalized KCC-1 and KIT-6 Mesoporous Silicas for Nd3+ Ion Recovery from Aqueous Solutions. J. Ind. Eng. Chem. 2018, 67, 210–218. [Google Scholar] [CrossRef]
- Prabhakar, M.N.; Raghavendra, G.M.; Vijaykumar, B.V.D.; Patil, K.; Seo, J.; Jung-il, S. Synthesis of a Novel Compound Based on Chitosan and Ammonium Polyphosphate for Flame Retardancy Applications. Cellulose 2019, 26, 8801–8812. [Google Scholar] [CrossRef]
- Zhao, J.; Liu, X.; Ren, X.; Du, B.; Kuang, X.; Tian, D.; Wei, Q.; Wu, D. Chromium Doping: A New Approach to Regulate Electronic Structure of Cobalt Carbonate Hydroxide for Oxygen Evolution Improvement. J. Colloid Interface Sci. 2022, 609, 414–422. [Google Scholar] [CrossRef]
- Ghosh, S.; Sarkar, B.; Thongmee, S.; Mostafavi, E. Hybrid Antibacterial, Antifungal, and Antiviral Smart Coatings. In Antiviral and Antimicrobial Smart Coatings; Kumar, A., Behera, A., Nguyen, T.A., Bilal, M., Gupta, R., Eds.; Elsevier: Amsterdam, The Netherlands, 2023; pp. 431–452. [Google Scholar]
- Stevanović, M.; Bajić, Z.J.; Veličković, Z.S.; Karkalić, R.M.; Pecić, L.; Otřísal, P.; Marinković, A.D. Adsorption Performances and Antimicrobial Activity of the Nanosilver Modified Montmorillonite Clay. Desalin. Water Treat. 2020, 187, 345–369. [Google Scholar] [CrossRef]
- Cantero, D.; Pinilla-Peñalver, E.; Romero, A.; Sánchez-Silva, L. Synthesis of Waterborne Polyurethane Aerogels-like Materials via Freeze-Drying: An Innovative Approach. J. Mater. Sci. 2023, 58, 9087–9102. [Google Scholar] [CrossRef]
- Muñoz-Bonilla, A.; Fernández-García, M. Polymeric Materials with Antimicrobial Activity. Prog. Polym. Sci. 2012, 37, 281–339. [Google Scholar] [CrossRef]
- Palenzuela, M.; Valenzuela, L.; Amariei, G.; Vega, J.F.; Mosquera, M.E.G.; Rosal, R. Poly(Glycidyl Methacrylate) Macromolecular Assemblies as Biocompatible Nanocarrier for the Antimicrobial Lysozyme. Int. J. Pharm. 2021, 603, 120695. [Google Scholar] [CrossRef]
- Fazaeli, Y.; Amani, V.; Amini, M.M.; Khavasi, H.R. Bis(tri benzyl ammonium) tetra chloridoaurate(III) chloride. Acta Cryst. E. 2010, 66, m212. [Google Scholar] [CrossRef]
- Groom, C.R.; Bruno, I.J.; Lightfoot, M.P.; Ward, S.C. The Cambridge Structural Database. Acta Cryst. B 2016, 72, 171–179. [Google Scholar] [CrossRef]

| Sample | SS,Hg, m2/g | VS, cm3/g | dV/2, nm |
|---|---|---|---|
| pGME | 58 | 0.53 | 51 |
| pGME-en | 84 | 0.80 | 78 |
| Model | Parameter | Value |
|---|---|---|
| Pseudo-first-order | Qecalc, mg/g | 183.67 |
| k1, 1/min | 0.13 | |
| R2 | 0.963 | |
| Pseudo-second-order | Qecalc, mg/g | 197.87 |
| k2 · 103, g/mg min | 1.01 | |
| R2 | 0.987 | |
| Elovich | α, mg/g min | 136.29 |
| β · 102, g/mg | 3.15 | |
| R2 | 0.915 | |
| Modified Freundlich | kMF · 102, L/g min | 3.75 |
| m | 4.85 | |
| R2 | 0.842 | |
| Avrami | kAV, 1/min | 0.12 |
| n | 0.74 | |
| Qecalc, mg/g | 187.80 | |
| R2 | 0.987 | |
| Liquid film diffusion | kLFD · 102, 1/min | 8.35 |
| CLFD | 0.29 | |
| R2 | 0.982 | |
| Intra-particle diffusion | kId, mg/g min0.5 | 3.78 |
| Cid | 157.12 | |
| R2 | 0.959 | |
| Bangham | kB · 103, 1/g | 0.47 |
| α | 0.46 | |
| R2 | 0.861 | |
| Boyd | R2 | 0.974 |
| Adsorbent * | pH | Qeexp, mg/g | teq, h | Ref. |
|---|---|---|---|---|
| Fe3O4@SiO2-NH2 | 2 | 14.10 | - | [50] |
| Amberlite XAD 7-L-glutamic acid | <4 | 14.23 | 1 | [51] |
| DACS-TA | <5.7 | 298.5 | 22 | [52] |
| RFT-SA | 3 | 386.5 | 18 | [53] |
| CPEIR | 2 | 943.5 | 12 | [54] |
| PE-PGMA | 3 | 99.08 | 0.2 | [55] |
| A-PGMA | 4 | 201.214 | 3 | [56] |
| pGME-en | 1.5 | 187.22 | 0.5 | This study |
| Test Organism | Inhibition Zone (ϕ mm) |
|---|---|
| Staphylococcus aureus ATCC a 25923 | 7.5 |
| Listeria monocytogenes NCTC b 11994 | 9.0 |
| Escherichia coli NCTC 2001 | - |
| Candida albicans ATCC 10231 | 8.0 |
Disclaimer/Publisher’s Note: The statements, opinions and data contained in all publications are solely those of the individual author(s) and contributor(s) and not of MDPI and/or the editor(s). MDPI and/or the editor(s) disclaim responsibility for any injury to people or property resulting from any ideas, methods, instructions or products referred to in the content. |
© 2023 by the authors. Licensee MDPI, Basel, Switzerland. This article is an open access article distributed under the terms and conditions of the Creative Commons Attribution (CC BY) license (https://creativecommons.org/licenses/by/4.0/).
Share and Cite
Tadić, T.; Marković, B.; Vuković, Z.; Stefanov, P.; Maksin, D.; Nastasović, A.; Onjia, A. Fast Gold Recovery from Aqueous Solutions and Assessment of Antimicrobial Activities of Novel Gold Composite. Metals 2023, 13, 1864. https://doi.org/10.3390/met13111864
Tadić T, Marković B, Vuković Z, Stefanov P, Maksin D, Nastasović A, Onjia A. Fast Gold Recovery from Aqueous Solutions and Assessment of Antimicrobial Activities of Novel Gold Composite. Metals. 2023; 13(11):1864. https://doi.org/10.3390/met13111864
Chicago/Turabian StyleTadić, Tamara, Bojana Marković, Zorica Vuković, Plamen Stefanov, Danijela Maksin, Aleksandra Nastasović, and Antonije Onjia. 2023. "Fast Gold Recovery from Aqueous Solutions and Assessment of Antimicrobial Activities of Novel Gold Composite" Metals 13, no. 11: 1864. https://doi.org/10.3390/met13111864
APA StyleTadić, T., Marković, B., Vuković, Z., Stefanov, P., Maksin, D., Nastasović, A., & Onjia, A. (2023). Fast Gold Recovery from Aqueous Solutions and Assessment of Antimicrobial Activities of Novel Gold Composite. Metals, 13(11), 1864. https://doi.org/10.3390/met13111864

